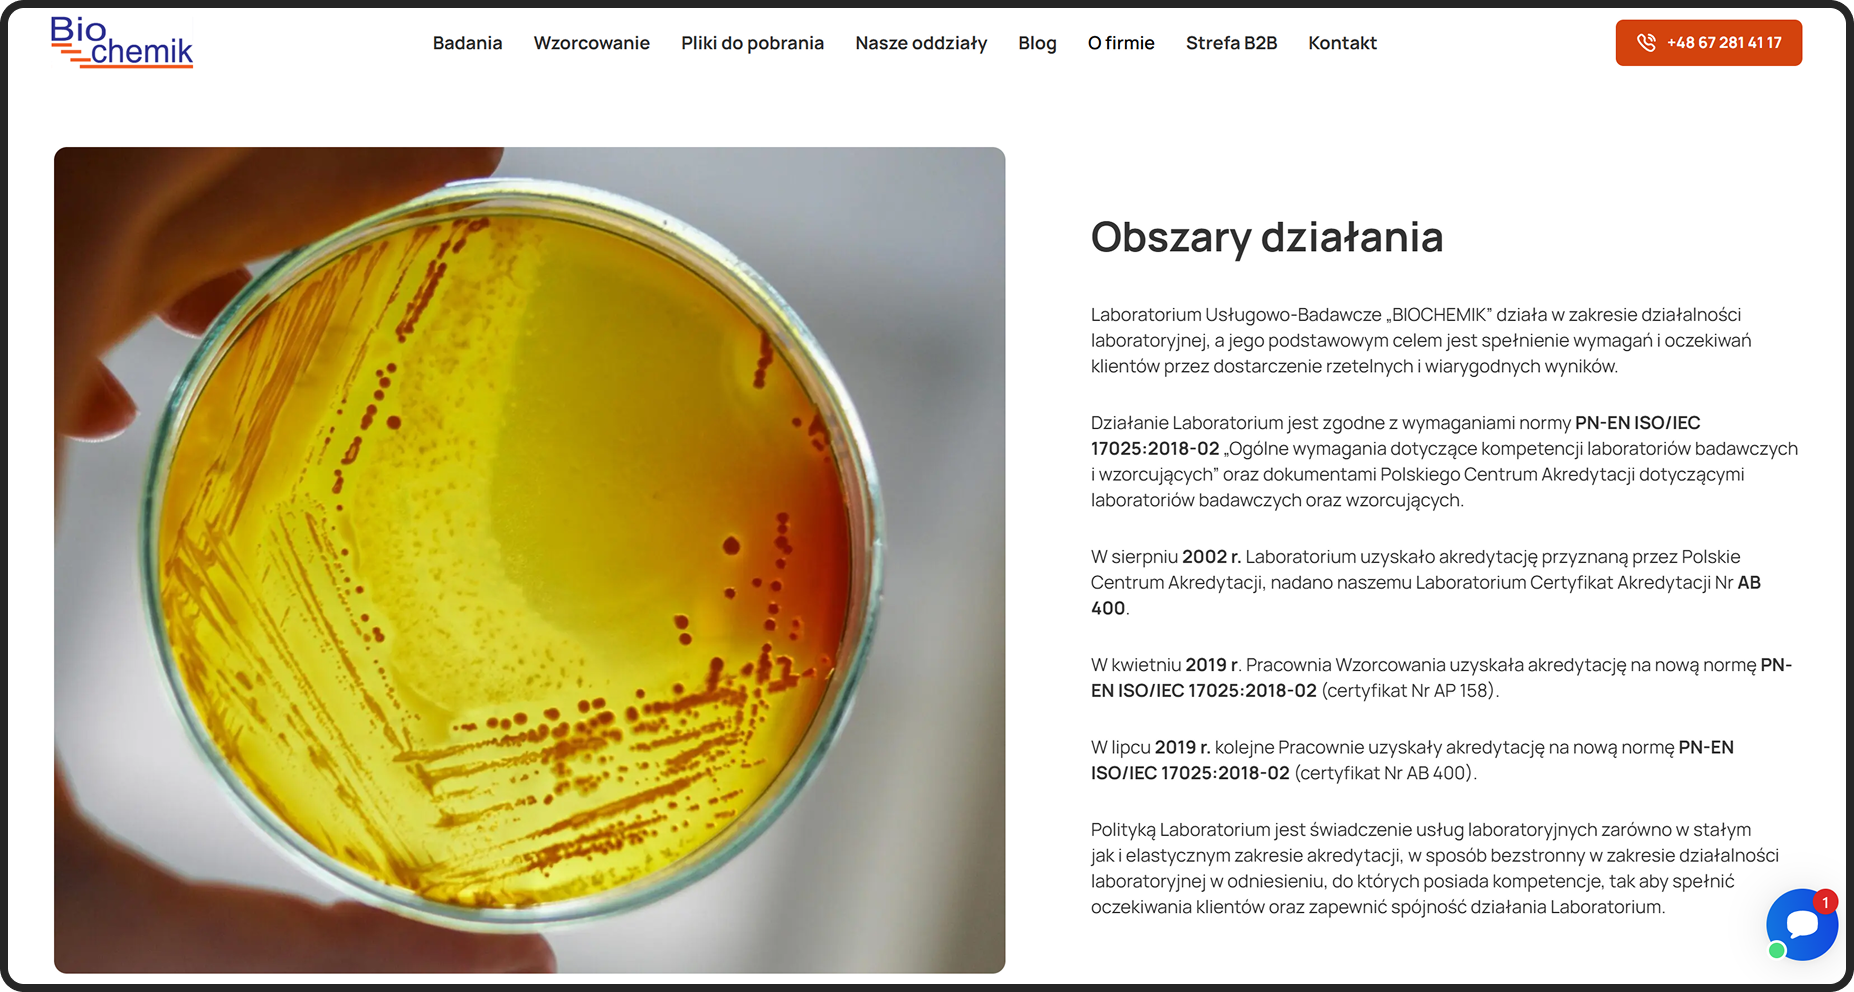
biochemik dedykowana strona www

Biochemik – nowoczesna strona internetowa dla branży laboratoryjnej
Dedykowana strona internetowa WordPress
Wykonany zakres prac
DEV
GFX
UX/UI

Szczegółowe informacje o projekcie strony:
- Branża: laboratoryjna,
- Zakres prac:
- UX Design – projekt UX – uporządkowanie rozbudowanego katalogu produktów, filtrowanie i intuicyjna nawigacja,
- UI Design – profesjonalny, czysty i techniczny layout dopasowany do charakteru branży,
- Programowanie WordPress – responsywne strony internetowe, strona oparta o CMS WordPress,
- optymalizacja szybkości strony i Core Web Vitals,
- Technologie: strony WordPress, optymalizacja pod kątem responsywności RWD, optymalizacja wydajności.
%nbsp;






Profesjonalna strona internetowa dla branży laboratoryjnej
Projekt dla Biochemik.pl wymagał stworzenia strony internetowej, która:
- skutecznie prezentuje szeroką gamę realizowanych przez firmę badań,
- ułatwia klientom szybkie znalezienie badań, którymi są zainteresowani,
- zapewnia pełną zgodność z wymaganiami branży laboratoryjnej: precyzyjne opisy, atrybuty, dokumentacja,
- strona jest maksymalnie prosta i intuicyjna dla użytkowników,
- prezentuje markę Biochemik jako solidną i nowoczesną firmę laboratoryjną.
Strony internetowe
WordPress
UX/UI
Cel projektu strony internetowej WordPress:
Skuteczna strona internetowa – efekty realizacji
- znacząca poprawa nawigacji w rozbudowanym katalogu produktów,
- bardziej przejrzyste strony ofert z badaniami – kluczowe dla klientów,
- szybszy proces znajdowania badań przekładający się na wygodę użytkowników,
- poprawione wyniki w Google dzięki optymalizacji szybkości i struktury treści,
- wzmocnienie wizerunku Biochemik.pl jako profesjonalnej firmy z branży laboratoryjnej
Chętnie porozmawiam
o Twoim projekcie


Sławomir Woźniak
New Business | PL